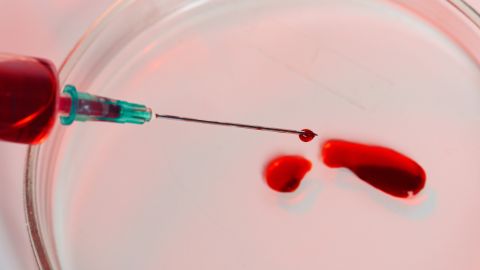

Le Blog Qualineo
+300 articles pour décrypter les évolutions réglementaires de votre secteur
Découvrez nos articles sur la démarche qualité et la gestion des risques
Thank you! Your submission has been received!
Oops! Something went wrong while submitting the form.

Ludopédagogie : l’apprentissage autrement, au cœur des pratiques qualité
Médico-social
Social
Sanitaire

Fiche de poste : un levier RH au service du recrutement dans le secteur de la santé
Médico-social
Sanitaire
Social
Imagerie
Biologie
Accident avec exposition au sang (AES) : quelle conduite à tenir ?
Médico-social
Sanitaire
Biologie